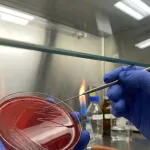
制药厂QC微生物限度与无菌检查实验室净化工程(GMP标准)
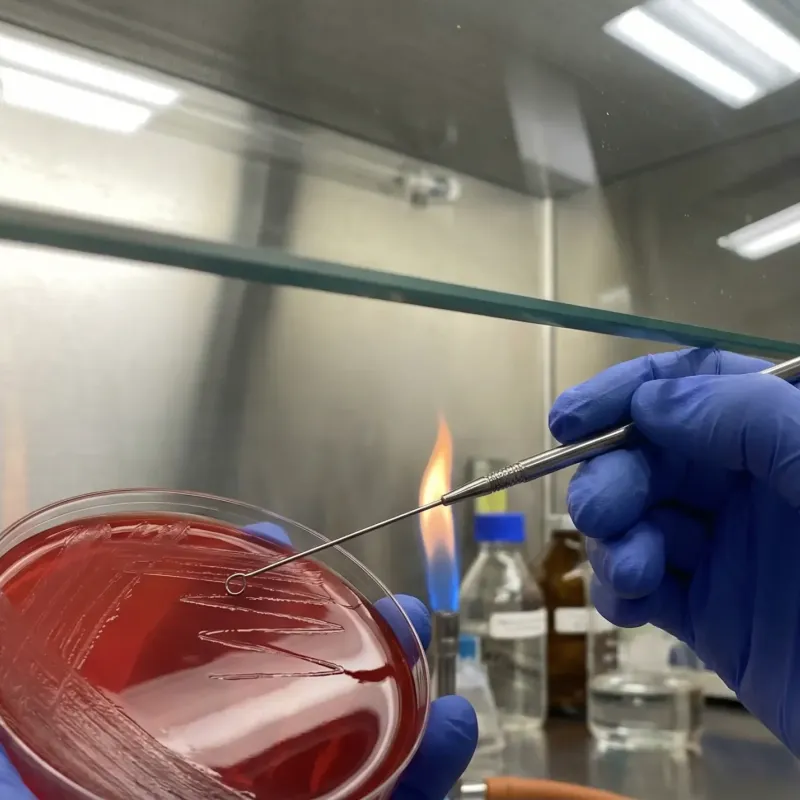
制药厂QC微生物限度与无菌检查实验室净化工程（GMP标准）

制药厂QC微生物限度与无菌检查实验室净化工程(GMP标准)
符合中国药典要求的微生物实验室。包含万级背景下的局部百级无菌室、微生物限度室及阳性对照室。通过独立的净化空调系统,实现了阳性菌室与无菌室的绝对隔离。
项目背景与难点: 药厂QC微生物实验室是药品放行的最后一道关卡。根据2020版《中国药典》,实验室需具备无菌检查(检测产品是否无菌)和微生物限度检查(检测细菌数量)功能,同时还必须设立阳性对照室(专门培养细菌)。工程最大的矛盾在于:如何在一个洁净区内,既要创造“绝对无菌”的环境,又要安全地控制“高浓度细菌”的阳性室,防止其交叉污染。
工程技术详解(解决方案):
- 独立回风与压差隔离策略: 我们设计了三套独立的风路系统。
- 无菌室/限度室: 维持相对正压(+15Pa),防止外部污染侵入。
- 阳性对照室: 必须设计为“相对洁净区的负压”(-10Pa),且采用全新风全排风系统(不回风)。排风经高效过滤后直排室外,确保阳性菌株绝不逃逸到走廊或通过回风管道污染无菌室。
- 核心区B+A设计: 在无菌检查室和微生物限度室内,我们在背景环境达到C级(或万级)的基础上,配置了A级层流罩(ISO 5级)或A级生物安全柜。操作台面风速严格控制在0.36-0.54m/s,通过烟雾流线测试验证,确保核心操作区气流为单向流,有效保护药品样本。
- 灭菌与废弃物通道: 设置了双扉高压灭菌柜(Pass-through Autoclave)嵌入墙体。阳性室产生的含菌废弃物,必须在室内先经过灭菌柜高温灭菌后,才能从另一侧门取出运走,从源头上切断了生物污染传播路径。
项目交付与成效: 实验室顺利通过了药品GMP现场检查认证。其严谨的压差控制和洁污分流设计,确保了长期运行中“无菌检查假阳性率”为零,为企业的药品质量控制提供了最坚实的硬件保障。